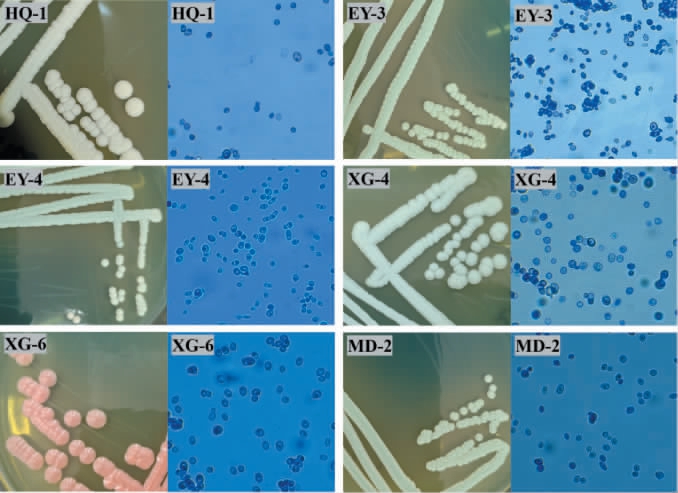

乳扇(milk fan)是云南大理地区富有民族特色的传统乳制品,以鲜牛奶为原料,用酸木瓜或青梅熬制的酸浆进行凝乳、拉伸、成型、干燥后制成,属于典型的酸凝型拉伸奶酪,独特的原料和加工工艺赋予乳扇独特的形状和风味,因外形薄如纸扇,得名乳扇[1]。 乳扇不仅风味独特,还含有丰富的微生物资源,目前,针对乳扇的研究主要集中在乳扇加工工艺与品质[2]、风味形成与变化[3]、乳扇保鲜等[4],而针对乳扇中的微生物,仅有少量关于乳扇中乳酸菌分离或酵母菌分离的研究报道,侯宇等[5]从乳扇中分离得到了5株乳酸菌,包括嗜热链球菌(Streptococcus thermophilus)、保加利亚乳杆菌(Lactobacillus bulgaricus)、副干酪乳杆菌(Lactobacillus paracasei)和干酪乳杆菌(Lactobacillus casei);杜永新等[6]从乳扇中分离得到1株唾液链球菌嗜热亚种(Streptococcus salivarius subsp.thermophilus)和1株德氏乳杆菌保加利亚亚种(Lactobacillus delbrueckii subsp.bulgaricus);赵英杰等[7]从乳扇中分离得到9株产胞外多糖酵母菌。
目前,针对乳扇中真菌菌群多样性的研究较少,对乳扇中的真菌尤其是酵母菌的研究更是鲜见,而大量的研究表明,乳制品中的酵母菌资源非常丰富[8],且已有研究大多采用单一方法分析乳扇中微生物的多样性,如采用传统培养分离方法分离菌种,或采用非培养方法研究微生物群落结构变化与乳扇风味的相关性等[9-10]。 高通量测序技术是近年来发展的一种分析环境中微生物多样性的非培养方法,因其价格低、测序周期短、准确性高,可以发现不可培养的微生物种类等[11],弥补了传统培养方法的不足,已经被广泛应用于解析植物、肠道、食品中的微生物多样性[12]。目前少有使用高通量测序技术和传统培养方法相结合来探索乳扇中真菌菌群多样性的研究。
为探究不同来源乳扇样品真菌菌群多样性及可培养酵母菌的差异,采用高通量测序技术对采集自云南省大理白族自治州4个地区的5个乳扇样品的真菌菌群多样性进行分析,并结合传统培养分离方法及分子生物学技术从乳扇样品中分离鉴定酵母菌菌株,以期阐明不同来源乳扇中真菌类群的差异特征,为针对性筛选并利用具有潜在优良性能的酵母菌的资源提供科学依据,同时为进一步推动高原特色产品产业的发展提供数据支撑。
1 材料与方法
1.1 材料与试剂
1.1.1 样品
5个乳扇样品:采自云南省大理白族自治州,分别标记为HQ(云南省大理白族自治州鹤庆县草海镇)、EY(云南省大理白族自治州洱源县右所镇)、EYM(云南省大理白族自治州洱源县右所镇,添加玫瑰花)、XG(云南省大理白族自治州大理市下关镇)、MD(云南省大理白族自治州弥渡县新街镇)。5个乳扇样品分别装入无菌样品袋中,低温运回实验室,-40 ℃冰箱保存备用。
1.1.2 试剂与培养基
马铃薯葡萄糖琼脂(potato dextrose agar,PDA)培养基、WL营养琼脂培养基:北京奥博星生物技术有限责任公司;无水乙醇(分析纯):成都市科隆化学品有限公司;E.Z.N.A.R Soil 脱氧核糖核酸(deoxyribonucleic acid,DNA)Kit:美国Omega公司;酵母基因组DNA快速抽提试剂盒、琼脂糖(电泳级):生工生物工程(上海)股份有限公司;DNA凝胶回收纯化试剂盒:中国逾华生物技术有限公司;2×ProTaq HS聚合酶链式反应(polymerase chain reaction,PCR)预混液:湖南艾科瑞生物工程有限公司;其他试剂均为国产分析纯。
1.2 仪器与设备
TST-RO-10离子交换纯水机、WPL-125BE电热恒温培养箱:天津市泰斯特仪器有限公司;LDZM-40KCS-11立式压力蒸汽灭菌锅:上海申安医疗器械厂;SW-CJ-2FD洁净工作台:苏州安泰空气技术有限公司;OLYMPUS CX33显微镜:日本奥林巴斯公司;ABI GeneAmpR 9700型PCR仪:美国ABI GeneAmp公司;JY600C电泳仪:北京君意东方电泳设备有限公司;NanoDrop2000超微量紫外/可见分光光度计:美国Thermo Scientific公司;Qubit4.0荧光定量仪:美国Life Invitrogen公司。
1.3 方法
1.3.1 乳扇样品宏基因组DNA抽提
根据E.Z.N.A.R Soil DNA Kit说明书进行微生物群落宏基因组DNA的抽提,使用1%的琼脂糖凝胶电泳检测宏基因组DNA的质量,使用NanoDrop2000测定DNA浓度和纯度。
1.3.2 PCR扩增
以提取的宏基因组DNA为模板,使用引物ITS1F(5'-CTTGGTCATTTAGAGGAAGTAA-3')和ITS2R(5'-GCTGCGTTCTTCATCGATGC')对真菌菌群的ITS区基因序列进行PCR扩增,PCR扩增体系:2×Pro Taq 10 μL,上游引物(5 μmol/L)0.8 μL,下游引物(5 μmol/L)0.8 μL,DNA模板10 ng,双蒸水(ddH2O)补足至20 μL。 PCR扩增程序:95 ℃预变性3 min,35个循环(95 ℃变性30 s,55 ℃退火30 s,72 ℃延伸45 s),72 ℃再延伸10 min,最后4 ℃保存。 使用2%琼脂糖凝胶回收PCR产物,利用DNA凝胶回收纯化试剂盒回收产物,并用Qubit4.0荧光定量仪检测回收产物的纯度和浓度。
1.3.3 高通量测序
委托上海美吉生物医药科技有限公司进行Illumina Nextseq2000高通量测序,测序后使用fastpv0.19.6软件(https://github.com/OpenGene/fastp)对双端原始测序序列进行质控,使用FLASH v 1.2.11软件(http://www.cbcb.umd.edu/software/flash)进行拼接。
1.3.4 乳扇样品中酵母菌的分离与纯化
分别称取乳扇样品10 g,加入装有90 mL无菌水的锥形瓶中,充分混匀,并以10倍梯度稀释法稀释至10-5,取不同稀释度的样品悬液100 μL涂布于PDA培养基平板上,倒置于28 ℃的恒温培养箱中培养3 d。使用接种环挑取具有典型酵母菌特征的单菌落,在WL营养琼脂培养基上划线纯化(培养条件同上),将纯化后的单菌落保藏在-80 ℃冰箱中。
1.3.5 酵母菌的分子生物学鉴定
使用酵母基因组DNA快速抽提试剂盒提取酵母菌的基因组DNA,采用1%琼脂糖凝胶电泳验证DNA质量后,以其为模板,采用通用引物NS 1(5'-GTATCATATGCTTGTCTC-3')和NS 8(5'-TCCGCAGGTTCACCTACGGA-3')对酵母菌的18S rDNA基因序列进行PCR扩增。PCR扩增体系及条件同方法1.3.2。采用1%琼脂糖凝胶对PCR扩增产物检测合格后,委托生工生物工程(上海)股份有限公司进行测序。 将测序结果提交至美国国家生物技术信息中心(national center for biotechnology information,NCBI)的GenBank数据库中,采用基本局部比对搜索工具(basic local alignment search tool,BLAST)进行同源性比对,选取同源性较高的模式菌株的18S rDNA基因序列,采用MEGA 7软件中的邻接法(neighbor-joining,NJ)构建系统发育树。
1.3.6 数据处理与分析
高通量测序得到的序列按照97%的相似度水平进行操作分类单元(operational taxonomic unit,OTU)聚类,在聚类过程中去除嵌合体,得到OTU的代表序列,采用RDP classifier贝叶斯算法对OTU代表序列进行分类学分析。基于美吉生物云平台(https://cloud.majorbio.com)进行真菌菌群多样性分析。使用SPSS 20.0软件进行单因素方差分析。
2 结果与分析
2.1 真菌菌群多样性分析
2.1.1 高通量测序结果分析
通过高通量测序从5个乳扇样品中共获得881 555条有效序列,平均序列长度为237 bp,划分为185个OTU,共注释到3个门、14个纲、26个目、46个科、78个属、115个种。为了判断测序数据量是否合理,基于OTU数绘制5个乳扇样品中真菌菌群的稀释曲线,结果见图1。由图1可知,随着测序深度的增加,所有乳扇样品的稀释曲线都趋于平缓,表明测序量可以反映样品中真菌群落的结构和多样性[13]。

图1 基于操作分类单元乳扇样品真菌菌群的稀释曲线
Fig.1 Dilution curves of fungal communities in Rushan samples based on operational taxonomic units
为了分析各个乳扇样品中共有和特有的真菌,绘制5个乳扇样品中真菌OTU韦恩图,结果见图2。由图2可知,样品XG中的OTU数最多,为137个,其次为样品MD,样品EY中的OTU数最少。5个样品共有OTU数为33个,除样品HQ与MD、EY与EYM与HQ、EY与EYM与MD没有共有OTU之外,其余样品间均有数目不等的共有OTU。样品XG、MD、EY、EYM和HQ特有OTU数分别为28个、12个、10个、8个和6个。结果表明,不同来源乳扇样品真菌群落结构存在一定的异同,差异可能是由于各乳扇样品的制作流程、制作环境不同引起的。

图2 不同来源乳扇样品真菌菌群操作分类单元韦恩图
Fig.2 Venn diagram of operational taxonomic units of fungal communities in Rushan samples from different sources
2.1.2 Alpha多样性分析
5个乳扇样品中真菌群落的Alpha多样性分析结果见表1。 Alpha多样性分析能够反映乳扇样品中真菌菌群的丰富度与均匀度。Coverage指数表示样品真菌群落的覆盖度;Ace指数和Chao1指数可反映群落的物种丰富度,数值越大,群落物种越丰富;Shannon指数和Simpson指数可反映样品中群落的多样性,Shannon指数越大,Simpson指数越小,表明样品中群落多样性越高,反之则越低[14]。
表1 不同来源乳扇样品中真菌菌群Alpha多样性分析
Table 1 Alpha diversity analysis of fungal communities in Rushan samples from different sources

注:同列不同小写字母表示差异显著(P<0.05)。下同。
样品编号Ace指数Chao 1指数Shannon指数Simpson指数Coverage/%HQ EY EYM XG MD 99.97 99.96 99.97 99.97 99.96 58.88±26.98b 86.30±31.25ab 68.57±7.79b 87.45±2.01ab 117.16±18.37a 56.20±27.24b 77.16±26.59ab 73.95±21.09ab 87.28±1.46ab 110.63±20.65a 1.03±0.17c 0.42±0.46c 1.46±0.11ab 1.33±0.31ab 2.00±0.54a 0.47±0.06b 0.87±0.16a 0.33±0.05b 0.44±0.13b 0.25±0.12b
由表1可知,5个样品的Coverage>99%,表明测序结果可以体现样品真菌群落多样性的实际情况;Ace指数为58~117,Chao 1指数为56~110,其中MD样品的Ace指数和Chao 1指数均最高,HQ样品的均最低;MD样品的Shannon指数最高,Simpson指数最低,而EY样品的Shannon指数最低,Simpson指数最高。结果表明,乳扇样品MD真菌菌群的丰富度和多样性都高于其他4个样品。样品XG的OTU数虽然最高,但其Ace指数、Chao1指数和Shannon指数均低于样品MD,因此,可以看出Alpha多样性各指数反映出来的乳扇样品中真菌菌群的丰富度与均匀度与样品OTU数目不呈正相关,这与兰林等[15]的分析结果一致。
2.1.3 真菌群落结构分析
为探究不同乳扇样品真菌群落在不同分类学水平上的组成情况,基于门和属水平对5个乳扇样品中的真菌群落结构进行分析,结果见图3。由图3A可知,5个乳扇样品中共注释到2个优势真菌门(平均相对丰度>1%),分别为子囊菌门(Ascomycota)(94.50%)和担子菌门(Basidiomycota)(5.49%)。 5个乳扇样品中子囊菌门的相对丰度均>80%,其中,子囊菌门在样品MD和EY中的相对丰度较高,分别达到98.74%和98.49%。担子菌门在样品XG中的相对丰度最高,为18.12%。

图3 基于门(A)和属水平(B)不同乳扇样品真菌菌群结构分析结果
Fig.3 Analysis results of fungal flora structure of different Rushan samples based on phylum level (A) and genus level (B)
Others:平均相对丰度排名30之后的其他属。
由图3B可知,在属水平上,5个乳扇样品中共注释到7个优势真菌属(平均相对丰度>1%),分别为假丝酵母属(Candida)(55.06%)、曲霉属(Aspergillus)(22.63%)、德巴利酵母属(Debaryomyces)(5.65%)、德克酵母属(Dekkera)(4.07%)、红酵母属(Rhodotorula)(3.38%)、棒孢酵母属(Clavispora)(2.35%)和克鲁维酵母属(Kluyveromyces)(1.20%)。Candida和Rhodotorula在所有乳扇样品中均存在,且Candida为样品HQ、EY和MD中的绝对优势菌属,其相对丰度均>65%。CHEN C等[10]通过高通量测序技术对昆明、玉溪、大理部分地区的乳扇样品的微生物多样性进行研究,发现其优势真菌属为Rhodotorula、有孢圆酵母属(Torulaspora)和Candida;梁晓琳等[16]通过高通量测序对传统发酵牦牛乳制品中微生物群落进行分析,结果表明,牦牛酸奶及曲拉中毕赤酵母属(Pichia)相对丰度较高,酸奶中还存在Kluyveromyces;刘敏等[17]采用高通量测序技术分析了蒙古族传统奶酪中的微生物菌群多样性,发现蒙古族传统奶酪中优势真菌属为地霉属(Geotrichum)、伊萨酵母属(Issatchenkia)、Kluyveromyces、未分类双足囊菌科、Pichia、Torulaspora和Dekkera。综上,不同乳制品、不同来源乳扇中的优势真菌属均有一定的差异,差异原因可能来自原料乳中蛋白质、脂肪、乳糖等成分含量的差别[18]。
不同乳扇样品中的优势真菌属(相对丰度>1%)具有一定的差异。样品HQ中的优势真菌属为Candida(69.26%)、Debaryomyces(22.26%)、路德酵母属(Lodderomyces)(1.51%)、Rhodotorula(1.34%)和丝孢酵母属(Trichosporon)(1.13%)。样品EY中的优势真菌属为Candida(92.73%)和Debaryomyces(3.43%)。 样品EYM中的优势真菌属为Aspergillus(92.98%)、Candida(2.79%)和Rhodotorula(1.18%)。样品XG中的优势真菌属为Candida(26.68%)、Dekkera(20.33%)、Aspergillus(18.29%)、Rhodotorula(13.11%)、Kluyveromyces(4.44%)、Geotrichum(3.03%)、Clavispora(2.79%)、Tausonia(2.30%)、Debaryomyces(2.23%)和Cutaneotrichosporon(1.22%)。样品MD中的优势真菌属为Candida(83.82%)、Clavispora(8.06%)、威克酵母属(Wickerhamiella)(2.90%)和Aspergillus(1.05%)。已有研究表明,Candida、Debaryomyces、Geotrichum、Rhodotorula、Clavispora、Trichosporon、Kluyveromyces等都是干酪型产品中的酵母种类,且一些酵母菌在原料乳(如牛奶)中已经被鉴定出来[19]。值得注意的是,添加玫瑰花的乳扇样品EYM中Aspergillus的相对丰度较其他样品高,有研究指出一些产脂肪酶和蛋白酶的曲霉菌与奶酪的后期成熟有关[20],但玫瑰花乳扇中曲霉菌的种类和作用有待进一步研究。与CHEN C等[10]的研究不同,本研究通过高通量测序从乳扇样品中首次分析出了Clavispora、Tausonia、Cutaneotrichosporon和Wickerhamiella等真菌属,且Clavispora在乳扇样品中为优势真菌属。Tausonia和Cutaneotrichosporon都是能够产生脂肪酶的酵母菌属[21-22],PÉTER G等[22]从乳品厂的空气中分离得到Cutaneotrichosporon属和Wickerhamiella的菌株可以同化半乳糖和葡萄糖[23],这几种酵母可能与乳扇中脂肪、乳糖等成分的降解及风味产生有关。
2.1.4 真菌群落Beta多样性分析
为了分析不同乳扇样品真菌群落组成差异,在OTU水平上进行样品真菌群落主坐标分析(principal co-ordinates analysis,PCoA),结果见图4。 由图4可知,PCoA1和PCoA2的方差贡献率分别为62.09%和18.86%,累计方差贡献率为80.95%,说明前两个成分能真实、可靠地反映样品的真菌菌群信息。其中,样品EY、MD、HQ分布在同一象限且距离较近,且样品MD与HQ交错分布,说明这3个样品的真菌群落组成差异性较小,结合乳扇样品在属水平的真菌群落结构(图3B),3个样品较高的相似性可能体现在其优势真菌属种类和相对丰度上。反之,样品XG分布在第一、二象限,样品EYM分布在第四象限,说明两者间且与其他样品间真菌群落组成差异较大。 样品EY和EYM来自同一采样地,两样品的真菌群落组成差异却较大,这可能与样品EYM中的玫瑰花有关系。 植物体内普遍存在内生菌[24],玫瑰花中也可能存在,这类外源菌群可能会影响乳扇的真菌群落;玫瑰花中含有的成分如多糖、蛋白质、氨基酸等,可能会为乳扇中的一些真菌提供原料乳之外的新营养源[25];玫瑰花中的黄酮、多酚等成分可能对某些菌群具有抑制作用,这些因素最终导致添加与不添加玫瑰花的乳扇中真菌群落组成的差异[26]。

图4 基于操作分类单元水平不同来源乳扇样品真菌群落的主坐标分析结果
Fig.4 Principal co-ordinates analysis results of fungal communities in Rushan samples from different sources based on operational taxonomic unit level
2.2 酵母菌的分离鉴定
采用传统培养分离方法对5个乳扇中的酵母菌进行了分离鉴定,结果从5个乳扇样品中共分离鉴定得到23株酵母菌,其中样品HQ中分离鉴定得到4株(HQ-1~HQ-4),样品EY中分离鉴定得到5株(EY-1~EY-5),样品EYM中分离鉴定得到2株(EYM-1~EYM-2),样品XG中分离鉴定得到7株(XG-1~XG-7),样品MD中分离鉴定得到5株(MD-1~MD-5),部分菌株的菌落形态及细胞形态见图5,基于18S rDNA构建的系统发育树见图6。
图5 部分酵母菌分离株的菌落形态及细胞形态
Fig.5 Colony morphology and cell morphology of some screened strains of yeast

图6 基于18S rDNA基因序列乳扇中酵母菌分离株的系统发育树
Fig.6 Phylogenetic tree of screened yeasts from Rushan based on 18S rDNA gene sequences
由图5可知,乳扇样品中分离得到的酵母菌菌落呈圆形,颜色大多为乳白色(如菌株EY-4和XG-4)或乳黄色(如菌株HQ-1、EY-3和MD-2),少数为粉红色(如菌株XG-6),菌落边缘整齐,表面光滑、湿润。细胞形态为圆形或椭圆形,均观察到出芽繁殖。
由图6可知,菌株EYM-2、EY-1、HQ-2、HQ-4、XG-3和XG-7与德尔布有孢圆酵母(Torulaspora delbrueckii)CBS 1146(NG_061300.1)聚于一支,亲缘关系最近;菌株EYM-1与乳酸克鲁维酵母(Kluyveromyceslactis)CICC1772(AY790534.1)聚于一支,亲缘关系最近;菌株HQ-1和XG-2与马克思克鲁维酵母(Kluyveromyces marxianus)MON-24(MT079142.1)聚于一支,亲缘关系最近;菌株EY-2与近平滑假丝酵母(Candida parapsilosis)XS2(KY118177.1)聚于一支,亲缘关系最近;菌株HQ-3、EY-3、EY-5、XG-1、XG-4、MD-1和MD-5与诞沫假丝酵母(Candidazeylanoides)JCM1627(AB013509.1)聚于一支,亲缘关系最近;菌株MD-4与喜仙人掌毕赤酵母(Pichia cactophila)SBM416(OR016142.1)聚于一支,亲缘关系最近;菌株EY-4、MD-2和MD-3与葡萄牙棒孢酵母(Clavispora lusitaniae)NRRL Y-11827(NG_065595.1)聚于一支,亲缘关系最近;菌株XG-5和XG-6与胶红酵母(Rhodotorula mucilaginosa)JGTA-R1(KU051691.1)聚于一支,亲缘关系最近。 综上,结合形态学特征及分子生物学鉴定结果,23株酵母菌归属于6个属8个种,分别是有孢圆酵母属(Torulaspora)的德尔布有孢圆酵母(Torulaspora delbrueckii)(HQ-2、HQ-4、EY-1、EYM-2、XG-3和XG-7,共6株)、克鲁维酵母属(Kluyveromyces)的乳酸克鲁维酵母(Kluyveromyces lactis)(EYM-1,共1株)和马克思克鲁维酵母(Kluyveromyces marxianus)(HQ-1和XG-2,共2株)、假丝酵母属(Candida)的近平滑假丝酵母(Candida parapsilosis)(EY-2,共1株)和诞沫假丝酵母(Candida zeylanoides)HQ-3、EY-3、EY-5、XG-1、XG-4、MD-1和MD-5,共7株)、毕赤酵母属(Pichia)的喜仙人掌毕赤酵母(Pichia cactophila)(MD-4,共1株)、棒孢酵母属(Clavispora)的葡萄牙棒孢酵母(Clavispora lusitaniae)(EY-4、MD-2和MD-3,共3株)和红酵母属(Rhodotorula)的胶红酵母(Rhodotorula mucilaginosa)(XG-5和XG-6,共2株)。 结果表明,乳扇样品中的酵母菌资源非常丰富,且不同来源乳扇样品中分离得到的酵母菌种存在差异,而原料乳是乳制品中微生物的主要来源[27],此外加工环境[28]也对乳扇中的微生物菌群有影响,乳扇中酵母菌种的差异可能与原料乳及采样地的环境有关[29]。
乳扇样品中分离得到最多的菌株为Candida,包括7株C. zeylanoides和1株C.parapsilosis, 这两种酵母被认为在奶酪成熟的前几周出现[30],C.zeylanoides具有同化乳酸及分解脂肪的能力,C.parapsilosis是一种食品来源的条件致病菌,有研究发现随着奶酪的成熟,C.parapsilosis将无法存活[31],因此,乳扇样品中得到的C.parapsilosis可能来自原料乳。T.delbrueckii、K.lactis和K.marxianus都是乳制品中常见的酵母菌种类,曾多次从奶酪中分离得到,这几种酵母都具有较好的乳糖分解能力[19]。R.mucilaginosa是奶酪中的常见菌[19],可能与奶酪的风味有关。P.cactophila具有较好的产香能力[32],研究人员在内蒙古牧区的酸马奶[33]和新疆牧区的干酪[34]中都曾分离得到该菌种,其可能与乳扇的特殊香气有关。柴艳兵等[35]从酸奶生产车间分离到C.lusitaniae,认为其与酸奶污染有关,而近期有研究发现,C.lusitaniae具有产蛋白酶的能力[36],可能与乳扇成熟有关。
3 结论
采用高通量测序技术对来自不同来源的5个乳扇样品的真菌群落多样性进行分析。结果表明,5个乳扇样品真菌群落的丰富度和多样性存在显著差异(P<0.05)。在门水平上,乳扇中优势真菌门为子囊菌门和担子菌门。 在属水平上,乳扇样品中共注释到7个优势真菌属(平均相对丰度>1%),包 括Candida、Aspergillus、Debaryomyces、Dekkera、Rhodotorula、Clavispora和Kluyveromyces;不同乳扇样品中的优势真菌属在种类和相对丰度上均有差别。通过传统培养分离方法结合分子生物学技术从5个乳扇样品中共分离鉴定得到23株酵母菌,分属于6个属8个种,分别是K.marxianus、T. delbrueckii、C. zeylanoides、C. parapsilosis、C. lusitaniae、K.lactis、R.mucilaginosa和P.cactophila。 其中C.zeylanoides、T.delbrueckii和C.lusitaniae是乳扇样品中的优势酵母分离株,分别分离到7株、6株和3株。 综上,不同来源乳扇真菌菌群多样性及可培养酵母菌组成均存在差异。通过高通量测序技术和传统培养分离方法,共同揭示了不同来源乳扇中真菌群落的多样性及可培养酵母菌的差异,这对针对性筛选不同来源乳扇中特有的潜在优良性能酵母菌资源、支撑高原特色乳扇品质调控具有重要意义。
[1]王金梅,杨远,苗永旺.白族乳扇加工制作历史与发展探讨[J].中国乳业,2019(6):69-72.
[2]廖紫玉,魏光强,田洋,等.基于HS-SPME-GC-MS分析加工方式对即食乳扇风味品质的影响[J].中国乳品工业,2022,50(3):14-21.
[3]王亚东,韩颢颖,韩兆盛,等.新鲜乳扇贮存期间关键香气组分变化分析[J].食品科学,2022,43(24):202-209.
[4]WEI G Q, TAO J F, FU X P, et al.Insights into the effect of complex phosphates on acid-induced milk fan gel properties: texture, rheological,microstructure,and molecular forces[J].J Dairy Sci,2024,107(11):9054-9073.
[5]侯宇,范金波,张明,等.乳扇菌群的PCR-DGGE分析及其中乳酸菌的分离与特性研究[J].食品工业科技,2016,37(14):181-186.
[6]杜永新,吴文娟,赵世伟,等.乳扇中乳酸菌的分离及其复配酸奶发酵剂制备研究[J].农产品加工,2025(12):65-70.
[7]赵英杰,张文平,吴剑梅,等.乳扇中高产胞外多糖酵母菌的筛选及其抗氧化活性[J].食品科学,2019,40(22):134-140.
[8]但霞,李玲,黄钰涵,等.乳源酵母种类及对乳制品作用的研究进展[J].中国乳品工业,2023,51(12):36-42.
[9]CHEN C,YAO W Q,YU H Y,et al.Dynamics of microbial communities associated with flavor formation during sour juice fermentation and the milk fan drying process[J].J Dairy Sci,2023,106(11):7432-7446.
[10]CHEN C,HUANG K,YU H Y,et al.The diversity of microbial communities in Chinese milk fan and their effects on volatile organic compound profiles[J].J Dairy Sci,2020,104(3):2581-2593.
[11]奉综涛,买地那·帕尔哈提,尹秀,等.西藏不同地区枸杞果实表皮和叶际微生物多样性研究[J].中国酿造,2025,44(2):150-157.
[12]伍亚龙,杨恺,史莓梅,等.高通量测序结合传统微生物培养研究酱醪中微生物多样性及群落变化[J].食品与发酵工业,2023,49(3):75-82.
[13]GU J S,LIU T J, HOU J, et al.Analysis of bacterial diversity and biogenic amines content during the fermentation processing of stinky tofu[J].Food Res Int,2018,111(5):689-698.
[14]张雷渊,张春强,李慧,等.制麦过程优势真菌分离鉴定及其群落结构和多样性分析[J].食品与发酵工业,2023,49(22):41-48.
[15]兰林,段树华,汪晟羽,等.基于高通量测序技术分析豆腐乳中微生物多样性[J].中国酿造,2023,42(1):31-36.
[16]梁晓琳,张哲川,王宇豪,等.传统发酵牦牛乳制品中微生物群落及其与代谢产物相关性[J].食品科学,2024,45(9):84-92.
[17]刘敏,林佳卫,焦昱玮,等.基于高通量测序技术分析蒙古族传统奶酪微生物菌群多样性[J].中国酿造,2024,43(3):116-120.
[18]吴云芳,王宏慧,徐建平,等.乳成分分析仪快速检测生乳营养成分[J].食品安全质量检测学报,2025,16(14):204-212.
[19]BINTSIS T.Yeasts in different types of cheese[J].AIMS Microbiol,2021,7(4):447-470.
[20]SUZUKI S,OHMORI H,HAYASHIDA S,et al.Lipase and protease activities in Koji cheeses surface-ripened with Aspergillus strains[J].Food Sci Technol Res,2021,27(3):543-549.
[21]GONG D L,CONG H,LIU S Y,et al.Transcriptome identification and analysis of fatty acid desaturase gene expression at different temperatures in Tausonia pullulans 6A7[J].Microorganisms,2023,11(12):2916-2930.
[22]PÉTER G,MOUNIER J,GARNIER L, et al. Cutaneotrichosporon suis sp.nov.,a lipolytic yeast species from food and food-related environment[J].Int J Syst Evol Microbiol,2019,69(8):2367-2371.
[23]KHUNNAMWONG P, KINGPHADUNG K, LOMTHONG T, et al.Wickerhamiella nakhonpathomensis f.a.sp.nov.,a novel ascomycetous yeast species isolated from a mushroom and a flower in Thailand[J].Int J Syst Evol Microbiol,2022,72(1):005191.
[24]张敏,张丽莉,王虹云,等.植物内生菌及其在番茄生长发育中的作用研究进展[J].中国瓜菜,2025,38(7):10-16.
[25]奚佳玉,刘文静,邵士俊,等.玫瑰花的研究进展及其质量标志物预测分析[J].现代食品科技,2024,40(12):435-442.
[26]毛静春,罗发美,代腾云,等.6种可食用花卉化学成分的测定及其抗氧化活性对比分析[J].食品安全质量检测学报,2025,16(12):294-302.
[27]韩闯闯,熊丽娜,鲍文娜,等.基于高通量测序对乳粉加工过程中微生物的研究[J].中国乳品工业,2024,52(7):17-22,34.
[28]罗建学,万长江,杨桂秀,等.加工环境对乳扇贮藏品质的影响[J].中国食品添加剂2024,35(10):125-130.
[29]霍路曼,张晓利,陈彦丽,等.生鲜乳样品及环境中微生物多样性研究[J].中国乳品工业,2024,52(10):43-46,63.
[30]COSENTINO S, FADDA M E, DEPLANO M, et al.Yeasts associated with Sardinian ewe's dairy products[J].Int J Food Microbiol,2001,69(1-2):53-58.
[31]JACQUES N, CASAREGOLA S.Safety assessment of dairy microorganisms:the hemiascomycetous yeasts[J].Int J Food Microbiol,2008,126(3):321-326.
[32]CELIN′ SKA E,BONIKOWSKI R, BIAŁAS W, et al. Pichia cactophila and Kluyveromyces lactis are highly efficient microbial cell factories of natural amino acid-derived aroma compounds[J].Molecules, 2018, 23(1):97-108.
[33]张晓旭,葛武鹏,梁秀珍,等.内蒙古和新疆牧区酸马奶中酵母菌的多样性及其优势菌发酵特性[J].食品科学,2016,37(17):156-162.
[34]LI Y H, WANG C Y, WANG J G.Diversity analysis of the yeast and fungal community structure in Kazak cheese from the Yili Pastoral Area in Xinjiang[J].Int Dairy J,2023,143:105672-105684.
[35]柴艳兵,李兴佳,张耀广,等.酸奶生产中酵母菌分布及产品污染研究[J].中国乳品工业,2018,46(5):61-64.
[36]DJEKRIF S D,EL HADEF EL OKKI A A K,BENNAMOUN L, et al.Production optimization, partial characterization, and gluten-digesting ability of the acidic protease from Clavispora lusitaniae PC3[J].Fermentation,2024,10(3):139-164.